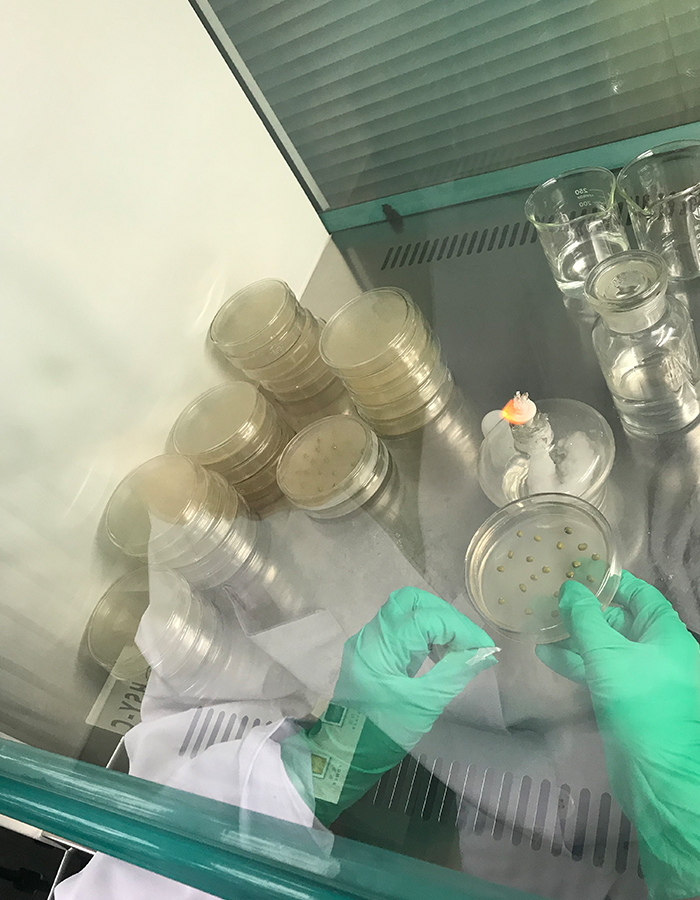
シャーレ　手
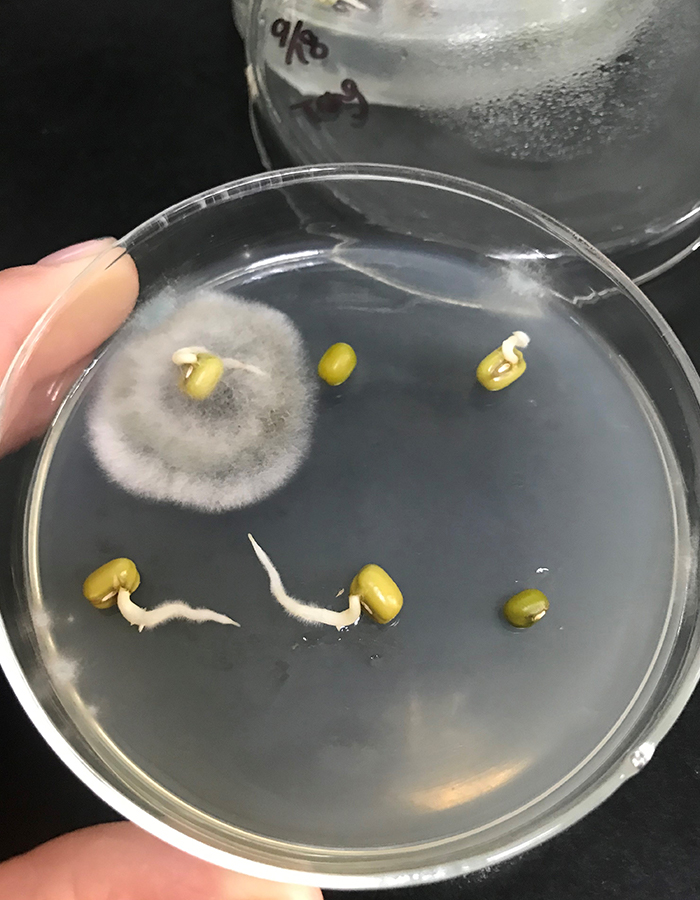
シャーレ　白カビ

緑豆
近年の気候変動により、緑豆の収穫時期に以前は降らなかった雨が降るようになりました。この雨によって日本で、もやしを発芽させた際にカビ、汚染などが見られるようになりました。カビなどが発生するかどうかは緑豆の見た目だけでは分かりません。
そのため大学院までバイオサイエンスを学んだ当社代表と中国の吉林農業大学研究室との協力で産地別の菌検出検査を行い、菌の検出の少ない産地のものだけを仕入れ販売しています。
菌検出検査方法
原料豆を70%エタノールに約10秒間、1%次亜塩素酸ナトリウム溶液に約1分間浸漬したものをブドウ糖加用ジャガイモ煎汁寒天平板培地(PDA培地)に置床し、1~2日培養して、分離源から伸長した単菌糸をかき取り、再度培養し、再純化し、菌の各種の形態を顕微鏡で観察します。
検査産地名
洮南、突泉、水泉、巴林左旗、通榆、科尔泌中旗、黄花山、扎魯特旗、敖漢の9箇所
各産地の「発芽原料緑豆検査結果説明表」を作成しております。
各産地の「発芽原料緑豆検査結果説明表」を作成しております。
検査菌名
炭腐病、根腐病、立枯病、クモノスカビなど